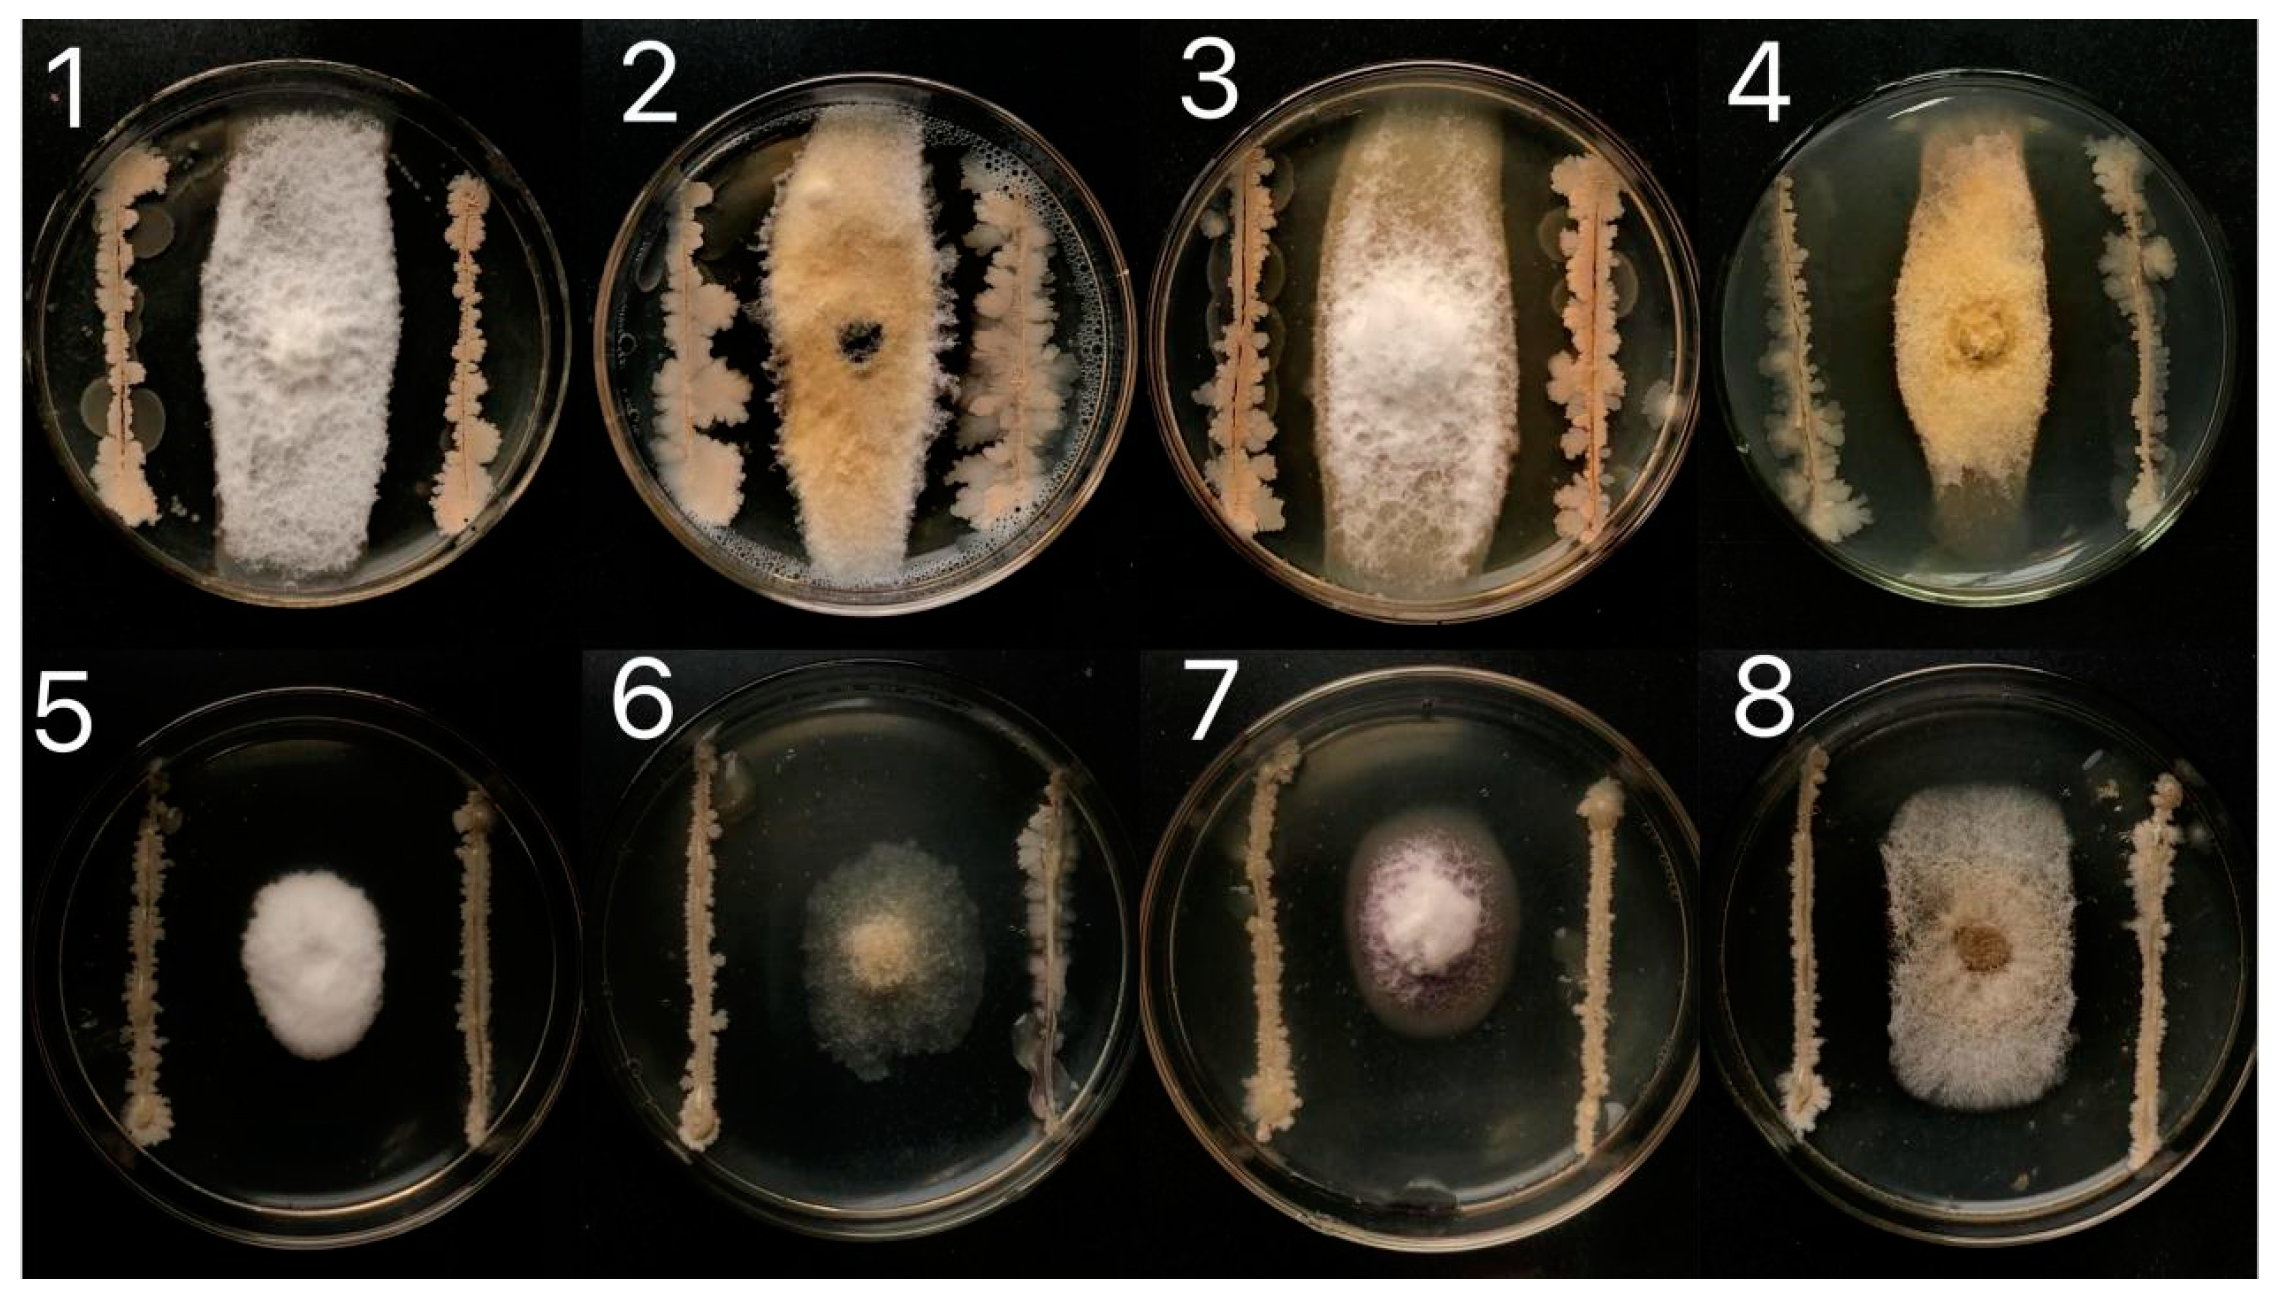
Agronomy 14 00167 g001

Biological Control Ability and Antifungal Activities of Bacillus velezensis Bv S3 against Fusarium oxysporum That Causes Rice Seedling Blight
Abstract
1. Introduction
2. Materials and Methods
2.1. Isolation of Bacterial Isolates
2.2. Screening of Biological Control Bacteria against RSB
2.3. Reduction of RSB by Biocontrol Bacterial Suspensions
2.4. Micro-Morphological Observation of Biocontrol Bacteria Bv S3
2.5. Identification of Biocontrol Bacteria Bv S3
2.6. Antifungal Spectrum
2.7. Effects of Bv S3 Filtrate on Conidial Germination, Mycelial Growth, and Morphology of F. oxysporum
2.8. Stability of Antifungal Substances
2.9. Effect of the Strain on Soil Enzyme Activity
2.10. Data Analysis
3. Results
3.1. Isolation and Screening of Biological Control Bacteria
3.2. Reduction of RSB following Application of Bv S3
3.3. Micro-Morphological Observation and Identification of Biocontrol Bacteria Bv S3
3.4. Stability of the Antifungal Substances in Bv S3
3.5. Effect of Bv S3 on the Hyphal and Conidia of F. oxysporum
3.6. Effects of Bv S3 Treatments on the Activities of Soil Neutral Phosphatase, Urease, Cellulase, Invertase, and Catalase
4. Discussion
5. Conclusions
Supplementary Materials
Author Contributions
Funding
Data Availability Statement
Conflicts of Interest
References
- Sarla, N.; Swamy, B.P.M. Oryza glaberrima: A source for the improvement of Oryza sativa. Curr. Sci. 2005, 89, 955–963. Available online: https://www.jstor.org/stable/24110748 (accessed on 25 September 2005).
- Cosslett, T.L.; Cosslett, P.D. Sustainable Development of Rice and Water Resources in Mainland Southeast Asia and Mekong River Basin; Springer: Singapore, 2020; Chapter 3. [Google Scholar]
- Xin, F.F.; Xiao, X.M.; Dong, J.W.; Zhang, G.L.; Zhang, Y.; Wu, X.C.; Li, X.G.; Zou, Z.H.; Ma, J.; Du, G.M.; et al. Large increases of paddy rice area, gross primary production, and grain production in Northeast China during 2000–2017. Sci. Total Environ. 2020, 711, 135183. [Google Scholar] [CrossRef] [PubMed]
- Clauss, K.; Yan, H.M.; Kuenzer, C. Mapping Paddy Rice in China in 2002, 2005, 2010 and 2014 with MODIS Time Series. Remote Sens. 2016, 8, 434. [Google Scholar] [CrossRef]
- Dong, J.; Xiao, X.; Zhang, G.; Menarguez, M.A.; Choi, C.Y.; Qin, Y.; Luo, P.; Zhang, Y.; Moore, B. Northward expansion of paddy rice in northeastern Asia during 2000–2014. Geophys. Res. Lett. 2016, 43, 3754–3761. [Google Scholar] [CrossRef]
- Zhang, G.L.; Xiao, X.M.; Biradar, C.M.; Dong, J.W.; Qin, Y.W.; Menarguez, M.A.; Zhou, Y.T.; Zhang, Y.; Jin, C.; Wang, J. Spatiotemporal patterns of paddy rice croplands in China and India from 2000 to 2015. Sci. Total Environ. 2017, 579, 82–92. [Google Scholar] [CrossRef] [PubMed]
- Liu, J.X.; Cai, Y.N.; Jiang, W.Y.; Li, Y.G.; Zhang, Q.F.; Pan, H.Y. Population Structure and Genetic Diversity of Fungi Causing Rice Seedling Blight in Northeast China Based on Microsatellite Markers. Plant Dis. 2020, 104, 868–874. [Google Scholar] [CrossRef] [PubMed]
- Ochi, A.; Konishi, H.; Ando, S.; Sato, K.; Yokoyama, K.; Tsushima, S.; Yoshida, S.; Morikawa, T.; Kaneko, T.; Takahashi, H. Management of bakanae and bacterial seedling blight diseases in nurseries by irradiating rice seeds with atmospheric plasma. Plant Pathol. 2017, 66, 67–76. [Google Scholar] [CrossRef]
- Li, Y.G.; Zhang, X.; Zhang, R.; Liu, J.X.; Ali, E.; Ji, P.S.; Pan, H.Y. Occurrence of Seedling Blight Caused by Fusarium tricinctum on Rice in China. Plant Dis. 2019, 103, 1789–1790. [Google Scholar] [CrossRef]
- Gaire, S.P.; Zhou, X.G.; Zhou, Y.; Shi, J.; Jo, Y.K. Identification and distribution of fungal pathogens associated with seedling blight of rice in the southern United States. Plant Pathol. 2023, 72, 76–88. [Google Scholar] [CrossRef]
- Yu, W.Q.; Li, P.; Wang, X.; Yan, F.C.; Huang, X.W.; Chen, P.; Liu, W.Z.; Zheng, G.P. Bio-control of Paenibacillus terrae NK3-4 Against Rice Seedling Blight. Mol. Plant Breed. 2021, 1, 11. [Google Scholar]
- Li, S.Z.; Chen, Y.; Yang, R.H.; Zhang, C.P.; Liu, Z.; Li, Y.L.; Chen, T.; Chen, G.Y.; Zou, L.F. Isolation and identification of a Bacillus velezensis strain against plant pathogenic Xanthomonas spp. Acta Microbio. Sin. 2019, 59, 1969–1983. [Google Scholar] [CrossRef]
- Rush, M.C. Chemical control of rice seedling disease. Annual Program Reporter La Rice. Exp. Stn. 1977, 69, 196–232. [Google Scholar]
- Bandong, J.M. Seed treatment for seedling blight control. Philipp. Pathol. 1985, 19, 13. [Google Scholar]
- Elsharkawy, M.M.; Hassan, N.; Ali, M.; Mondal, S.N.; Hyakumachi, M. Effect of zoysiagrass rhizosphere fungal isolates on disease suppression and growth promotion of rice seedlings. Acta Agric. Scand. Sect. B—Soil Plant Sci. 2014, 64, 135–140. [Google Scholar] [CrossRef]
- Solis, R.; Bertani, I.; Degrassi, G.; Devescovi, G.; Venturi, V. Involvement of quorum sensing and RpoS in rice seedling blight caused by Burkholderia plantarii. FEMS Microbiol. Lett. 2006, 259, 106–112. [Google Scholar] [CrossRef]
- Wang, M.; Wei, P.; Cao, M.; Zhu, L.; Lu, Y. First Report of Rice Seedling Blight Caused by Burkholderia plantarii in North and Southeast China. Plant Dis. 2016, 100, 645–646. [Google Scholar] [CrossRef]
- El-Shafey, R.A.S.; Attia, K.A.; Mostafa, F.A.; Elamawic, R.M. Incidence and Molecular Identification of Cochliobolus carbonum as Causal Organism of Rice Seedling Blight. Beni-Suef Univ. J. Basic Appl. Sci. 2018, 7, 652–662. [Google Scholar] [CrossRef]
- Gaire, S.P.; Zhou, X.G.; Jo, Y.K. Sterile White Basidiomycete Fungus Marasmius graminum: A New Pathogen Causing Seedling Blight in Rice. Plant Dis. 2020, 105, 702. [Google Scholar] [CrossRef]
- Wang, S.; Sun, L.; Li, W.Q.; Liu, J.X.; Li, Y.G.; Wei, D. First Report of Seedling Blight Caused by Fusarium redolens on Rice in Northeast China. Plant Dis. 2019, 103, 1418. [Google Scholar] [CrossRef]
- Xue, Y.; Hu, M.; Chen, S.S.; Hu, A.; Li, S.M.; Han, H.Y.; Lu, G.T.; Zeng, L.S.; Zhou, J.N. Enterobacter asburiae and Pantoea ananatis Causing Rice Bacterial Blight in China. Plant Dis. 2021, 105, 2078–2088. [Google Scholar] [CrossRef]
- Liu, J.X.; Zhang, R.S.; Xu, C.Z.; Liu, C.L.; Zheng, Y.Y.; Zhang, X.; Liu, S.; Li, Y.G. Characterisation of Pythium aristosporum Oomycete—A Novel Pathogen Causing Rice Seedling Blight in China. J. Fungi 2022, 8, 890. [Google Scholar] [CrossRef]
- Cao, Y.; Ding, W.; Liu, C. Unraveling the Metabolite Signature of Endophytic Bacillus velezensis Strain Showing Defense Response towards Fusarium oxysporum. Agronomy 2021, 11, 683. [Google Scholar] [CrossRef]
- Iguchi, K.; Takeuchi, T. Occurrence and control of benomyl resistant strains of Fusarium moniliformaem, the causal fungal of bakanae disease in Chiba prefecture. Bull. Chiba-Ken. Agric. Exp. Stn. 1988, 29, 115–123. [Google Scholar]
- Nasir, M.; Iqbal, B.; Hussain, M.; Mustafa, A.; Ayub, M. Chemical management of bacterial leaf blight disease in rice. J. Agric. Res. 2019, 57, 99–103. [Google Scholar]
- Williamson, S.M.; Guzman, M.; Marin, D.H.; Anas, O.; Jin, X.; Sutton, T.B. Evaluation of Pseudomonas syringae strain ESC-11 for biocontrol of crown rot and anthracnose of banana. Biol. Control 2008, 46, 279–286. [Google Scholar] [CrossRef]
- Shenashen, M.; Derbalah, A.; Hamza, A.; Mohamed, A.; El Safty, S. Antifungal activity of fabricated mesoporous alumina nanoparticles against root rot disease of tomato caused by Fusarium oxysporium. Pest Manag. Sci. 2017, 73, 1121–1126. [Google Scholar] [CrossRef]
- Ren, J.G.; Wang, J.L.; Cai, J. Effects of Fenaminosulf on Growth of Pepper (Capsicum annuum L.), Microbial Communities and Enzymatic Activities of the Soil Infested with Fusarium oxysporum. Indian J. Pharm. Sci. 2021, 83, 163–169. [Google Scholar] [CrossRef]
- Zhang, C.Y.; Wang, W.W.; Xue, M.; Liu, Z.; Zhang, Q.M.; Hou, J.M.; Xing, M.Y.; Wang, R.; Liu, T. The Combination of a Biocontrol Agent Trichoderma asperellum SC012 and Hymexazol Reduces the Effective Fungicide Dose to Control Fusarium Wilt in Cowpea. J. Fungi 2021, 7, 685. [Google Scholar] [CrossRef]
- Rasul, M.; Yasmin, S.; Zubair, M.; Mahreen, N.; Yousaf, S.; Arif, M.; Sajid, Z.I.; Mirza, M.S. Phosphate solubilizers as antagonists for bacterial leaf blight with improved rice growth in phosphorus deficit soil. Biol. Control 2019, 136, 103997. [Google Scholar] [CrossRef]
- Zhou, Z.C.; Tang, X.Y.; Peng, L.J.; Ding, H.X. Complete genome sequence of Bacillus velezensis GUAL210, a potential biocontrol agent isolated from pepper rhizosphere. Plant Dis. 2023, 107, 915–918. [Google Scholar] [CrossRef]
- Chen, Z.; Ding, W.; Wang, H.B. Study on bacteriostasis of compound microorganism preparation on rice blight pathogen and its application in field. J. Northeast Agric. Univ. 2015, 46, 22–27. [Google Scholar]
- Tao, Z.Y.; Xie, G.X.; Zeng, H.X.; Xu, F.S.; Xie, G.L. Paenibacillus alvei ZJU2011-1 as a biocontrol agent against corm rot of saffron caused by Fusarium oxysporum. Acta Phytophy Sin. 2013, 40, 285–286. [Google Scholar]
- Dimkic, I.; Janakiev, T.; Petrovic, M.; Degrassi, G.; Fira, D. Plant-associated Bacillus and Pseudomonas antimicrobial activities in plant disease suppression via biological control mechanisms-A review. Physiol. Mol. Plant Pathol. 2022, 117, 101754. [Google Scholar] [CrossRef]
- Fan, B.; Wang, C.; Song, X.F.; Ding, X.L.; Wu, L.M.; Wu, H.J.; Gao, X.W.; Borriss, R. Bacillus velezensis FZB42 in 2018: The Gram-Positive Model Strain for Plant Growth Promotion and Biocontrol. Front Microbiol. 2018, 9, 2491. [Google Scholar] [CrossRef] [PubMed]
- Cawoy, H.; Debois, D.; Franzil, L.; De Pauw, E.; Thonart, P.; Ongena, M. Lipopeptides as main ingredients for inhibition of fungal phytopathogens by Bacillus subtilis/amyloliquefaciens. Microb. Biotechnol. 2015, 8, 281–295. [Google Scholar] [CrossRef]
- Dihazi, A.; Jaiti, F.; Taktak, W.; Kilani-Feki, O.; Jaoua, S.; Driouich, A.; Baaziz, M.; Daayf, F.; Amine Serghini, M. Use of two bacteria for biological control of bayoud disease caused by Fusarium oxysporum in date palm (Phoenix dactylifera L.) seedlings. Plant Physiol. Bioch. 2012, 55, 7–15. [Google Scholar] [CrossRef] [PubMed]
- Perez, K.J.; Viana, J.D.; Lopes, F.C.; Pereira, J.Q.; dos Santos, D.M.; Oliveira, J.S.; Velho, R.V.; Crispim, S.M.; Nicoli, J.R.; Brandelli, A.; et al. Bacillus spp. Isolated from Puba as a Source of Biosurfactants and Antimicrobial Lipopeptides. Front. Microbiol. 2017, 8, 61. [Google Scholar] [CrossRef] [PubMed]
- Li, Y.G.; Cai, Y.N.; Liang, Y.B.; Ji, P.S.; Xu, L.K. Assessment of antifungal activities of a biocontrol bacterium BA17 for managing postharvest gray mold of green bean caused by Botrytis cinerea. Postharvest Biol. Technol. 2020, 161, 111086. [Google Scholar] [CrossRef]
- Birber, B.; Nueske, J.; Ritzau, M.; Grafe, U. Alnumycin, a new naphthoquinone antibiotic produced by an endophytic Streptomyces sp. J. Antibiot. 1998, 51, 381–382. [Google Scholar] [CrossRef]
- Schaad, N.W.; Jones, J.B.; Chun, W. Laboratory Guide for Identification of Plant Pathogenic Bacteria, 3rd ed.; American Phytopathological Society Press: St. Paul, MN, USA, 2001. [Google Scholar]
- Buchanan, R.E. Berger Bacterial Identification Manual; Science Press: Beijing, China, 1984. [Google Scholar]
- Dong, X.Z.; Cai, M.Y. Handbook of Systematic Identification of Common Bacteria; Science Press: Beijing, China, 2001. [Google Scholar]
- Baharudin, M.M.A.; Ngalimat, M.S.; Shariff, F.M.; Yusof, Z.N.B.; Karim, M.; Baharum, S.N.; Sabri, S. Antimicrobial activities of Bacillus velezensis strains isolated from stingless bee products against methicillin-resistant Staphylococcus aureus. PLoS ONE 2021, 16, 5. [Google Scholar] [CrossRef]
- Nei, M.; Kumar, S. Molecular Evolution and Phylogenetics; Oxford University Press: Oxford, UK, 2000; Volume 333. [Google Scholar]
- Li, B.; Zheng, Y.Y.; Cai, Y.N.; Liu, J.X.; Wang, R.T.; Cui, G.W.; Li, Y.G.; Meng, L. Identification and Assessment of a Biocontrol Agent, Ochrobactrum intermedium I-5, for Management of Alfalfa Root Rot Caused by Fusarium tricinctum. Phytopathology 2021, 111, 1927–1934. [Google Scholar] [CrossRef] [PubMed]
- Ruiz-García, C.; Béjar, V.; Martínez-Checa, F.; Llamas, I.; Quesada, E. Bacillus velezensis sp. nov., a surfactant-producing bacterium isolated from the river Vélez in Málaga, southern Spain. Int. J. Syst. Evol. Microbiol. 2005, 55, 191–195. [Google Scholar] [CrossRef] [PubMed]
- Wang, S.; Sun, L.; Zhang, W.; Chi, F.Q.; Hao, X.Y.; Bian, J.Y.; Li, Y.G. Bacillus velezensis BM21, a potential and efficient biocontrol agent in control of corn stalk rot caused by Fusarium graminearum. Egypt. J. Biol. Pest Control 2020, 30, 9. Available online: https://ejbpc.springeropen.com/articles/10.1186/s41938-020-0209-6 (accessed on 3 March 2020). [CrossRef]
- Wang, J.Z.; Qu, F.; Liang, J.Y.; Yang, M.F.; Hu, X.H. Bacillus velezensis SX13 promoted cucumber growth and production by accelerating the absorption of nutrients and increasing plant photosynthetic metabolism. Sci. Hortic. 2022, 301, 111151. [Google Scholar] [CrossRef]
- Kakar, K.U.; Nawaz, Z.; Cui, Z.; Almoneafy, A.A.; Ullah, R.; Shu, Q.Y. Rhizosphere-associated Alcaligenes and Bacillus strains that induce resistance against blast and sheath blight diseases, enhance plant growth and improve mineral content in rice. J. Appl. Microbiol. 2018, 124, 779–796. [Google Scholar] [CrossRef] [PubMed]
- Wang, M.C.; Hashimoto, M.; Hashidoko, Y. Carot-4-en-9,10-Diol, a Conidiation-Inducing Sesquiterpene Diol Produced by Trichoderma virens PS1-7 upon Exposure to Chemical Stress from Highly Active Iron Chelators. Appl. Environ. Microb. 2013, 79, 1906–1914. [Google Scholar] [CrossRef]
- Wan, M.G.; Li, G.Q.; Zhang, J.B.; Jiang, D.H.; Huang, H.C. Effect of volatile substances of Streptomyces platensis F-1 on control of plant fungal diseases. Biol. Control 2008, 46, 552–559. [Google Scholar] [CrossRef]
- Adachi, N.; Tsukamoto, S.; Inoue, Y.; Azegami, K. Control of Bacterial Seedling Rot and Seedling Blight of Rice by Bacteriophage. Plant Dis. 2012, 96, 1033–1036. [Google Scholar] [CrossRef]
- Verma, S.K.; Kingsley, K.L.; Bergen, M.S.; Kowalski, K.P.; White, J.F. Fungal Disease Prevention in Seedlings of Rice (Oryza sativa) and Other Grasses by Growth-Promoting Seed-Associated Endophytic Bacteria from Invasive Phragmites australis. Microorganisms 2018, 6, 21. [Google Scholar] [CrossRef]
- Zhang, R.S.; Wang, F.G.; Qi, Z.Q.; Qiao, J.Q.; Du, Y.; Yu, J.J.; Yu, M.N.; Liang, D.; Song, T.Q.; Yan, P.X.; et al. Iturins produced by Bacillus velezensis Jt84 play a key role in the biocontrol of rice blast disease. Biol. Control 2022, 174, 101302. [Google Scholar] [CrossRef]
- Gonzalez-Sanchez, M.A.; Perez-Jimenez, R.M.; Pliego, C.; Ramos, C.; de Vicente, A.; Cazorla, F.M. Biocontrol bacteria selected by a direct plant protection strategy against avocado white root rot show antagonism as a prevalent trait. J. Appl. Microbiol. 2010, 109, 65–78. [Google Scholar] [CrossRef] [PubMed]
- Aguilar, M.O.; Alvarez, F.; Medeot, D.; Jofré, E.; Semorile, L.; Pistorio, M. Screening of epiphytic rhizosphere-associated bacteria in Argentinian Malbec and Cabernet-Sauvignon vineyards for potential use as biological fertilisers and pathogen-control agents. Oeno One 2021, 55, 145–157. [Google Scholar] [CrossRef]
- Alsohim, A.S. Influence of Pseudomonas fluorescens mutants produced by transposon mutagenesis on in vitro and in vivo biocontrol and plant growth promotion. Egypt. J. Biol. Pest Control 2020, 30, 1. [Google Scholar] [CrossRef]
- Moto, M.S.; Gomes, C.B.; Souza, I.T.; Moura, A.B. Bacterial selection for biological control of plant disease: Criterion determination and validation. Braz. J. Microbiol. 2017, 48, 62–70. [Google Scholar] [CrossRef]
- Agaras, B.C.; Scandiani, M.; Luque, A.; Fernández, L.; Farina, F.; Carmona, M.; Gally, M.; Romero, A.; Wall, L.; Valverde, C. Quantification of the potential biocontrol and direct plant growth promotion abilities based on multiple biological traits distinguish different groups of Pseudomonas spp. Isolates. Biol. Control 2015, 90, 173–186. [Google Scholar] [CrossRef]
- Chávez-Díaz, I.F.; Angoa-Pérez, V.; López-Díaz, S.; Velázquez-Del Valle, M.G.; Hernández-Lauzardo, A.N. Antagonistic bacteria with potential for biocontrol on Rhizopus stolonifer obtained from blackberry fruits. Fruits 2014, 69, 41–46. [Google Scholar] [CrossRef]
- Liu, Y.; Teng, K.; Wang, T.; Dong, E.; Zhang, M.; Tao, Y.; Zhong, J. Antimicrobial Bacillus velezensis HC6: Production of three kinds of lipopeptides and biocontrol potential in maize. J. Appl. Microbiol. 2020, 128, 242–254. [Google Scholar] [CrossRef] [PubMed]
- Rabbee, M.F.; Ali, M.S.; Choi, J.; Hwang, B.S.; Jeong, S.C.; Baek, K.H. Bacillus velezensis: A Valuable Member of Bioactive Molecules within Plant Microbiomes. Molecules 2019, 24, 1046. [Google Scholar] [CrossRef]
- Pandin, C.; Darsonval, M.; Mayeur, C.; Le Coq, D.; Aymerich, S.; Briandet, R. Biofilm Formation and Synthesis of Antimicrobial Compounds by the Biocontrol Agent Bacillus velezensis QST713 in an Agaricus bisporus Compost Micromodel. Appl. Environ. Microb. 2019, 85, e00327-19. [Google Scholar] [CrossRef]
- Dunlap, C.A.; Bowman, M.J.; Rooney, A.P. Iturinic lipopeptide diversity in the Bacillus subtilis species group-important antifungals for plant disease biocontrol applications. Front. Microbiol. 2019, 10, 1794. [Google Scholar] [CrossRef]
- Rabbee, M.F.; Baek, K.H. Antimicrobial activities of lipopeptides and polyketides of Bacillus velezensis for agricultural applications. Molecules 2020, 25, 4973. [Google Scholar] [CrossRef] [PubMed]
- Yin, X.T.; Li, T.G.; Jiang, X.L.; Tang, X.N.; Zhang, J.K.; Yuan, L.F.; Wei, Y.F. Suppression of Grape White Rot Caused by Coniella vitis Using the Potential Biocontrol Agent Bacillus velezensis GSBZ09. Pathogens 2022, 11, 248. [Google Scholar] [CrossRef] [PubMed]
- Hasan, N.; Farzand, A.; Zhou, H.; Khan, U.I.; Moosa, A.; Zubair, M.; Yang, N.; Sun, Y.; Tang, C.M. Antagonistic Potential of Novel Endophytic Bacillus Strains and Mediation of Plant Defense against Verticillium Wilt in Upland Cotton. Plants 2020, 9, 1438. [Google Scholar] [CrossRef] [PubMed]
- Hamaoka, K.; Aoki, Y.; Suzuki, S. Isolation and Characterization of Endophyte Bacillus velezensis KOF112 from Grapevine Shoot Xylem as Biological Control Agent for Fungal Diseases. Plants 2021, 10, 1815. [Google Scholar] [CrossRef]
- Sarwar, A.; Hassan, M.N.; Imran, M.; Iqbal, M.; Majeed, S.; Brader, G.; Sessitsch, A.; Hafeez, F.Y. Biocontrol activity of surfactin A purified from Bacillus NH-100 and NH-217 against rice bakanae disease. Microbiol. Res. 2018, 209, 1–13. [Google Scholar] [CrossRef]
- Fujita, S.; Yokota, K. Disease suppression by the cyclic lipopeptides iturin A and surfactin from Bacillus spp. against Fusarium wilt of lettuce. J. Gen. Plant Pathol. 2019, 85, 44–48. Available online: https://link.springer.com/article/10.1007/s10327-018-0816-1 (accessed on 22 January 2019). [CrossRef]
- Thimon, L.; Peypoux, F.; Wallach, J.; Michel, G. Effect of the lipopeptide antibiotic, iturin A, on morphology and membrane ultrastructure of yeast cells. FEMS Microbiol. Lett. 1995, 128, 101–106. [Google Scholar] [CrossRef] [PubMed]
- Wang, X.Q.; Bi, X.F.; Xie, X.F.; Xing, Y.G.; Li, M.Y. Antibacterial effect of iturin A on strawberry spoilage mold. NPRD 2020, 32, 1889–1895. [Google Scholar]
- Liu, W.X.; Sun, C.M. C-17-fengycin B, produced by deep-sea-derived Bacillus subtilis, possessing a strong antifungal activity against Fusarium solani. Chin. J. Oceanol. Limn. 2021, 39, 1938–1947. Available online: https://link.springer.com/article/10.1007/s00343-020-0215-2 (accessed on 6 May 2021). [CrossRef]
- Wang, J.H.; Quan, C.S.; Xu, H.T.; Fan, S.D. Antifungal Characterization of Bacillus amyloliquefaciens Q-12. Food Ferm. Indt. 2006, 32, 47–50. [Google Scholar]
- Hwang, C.S.; Kim, H.H.; Oh, B.C.; Kim, Y.S.; Shin, D.H. Identification and Characteristics of Microorganism isolated from spoiled Red Bean paste. Food Sci. Biotechnol. 2004, 13, 758–761. [Google Scholar]
- Huang, X.; Zhang, R.C.; Wang, H.J.; Huang, R.S.; Huang, S.S. Antagonistic Ability against Lichi Colletrichum gloeosporiodes Penz of Crude Extract of Bacillus subtilis ON-6. Chin. Agri. Sci. Bull. 2011, 27, 188–193. [Google Scholar]
- Xu, T.; Zhu, T.H.; Li, S.J. beta-1,3-1,4-glucanase gene from Bacillus velezensis ZJ20 exerts antifungal effect on plant pathogenic fungi. World J. Microb. Biot. 2016, 32, 26. [Google Scholar] [CrossRef] [PubMed]
- Kremer, R.J.; Li, J.M. Developing weed-suppressive soils through improved soil quality management. Soil Tillage Res. 2003, 72, 193–202. [Google Scholar] [CrossRef]
- Pertile, M.; Antunes, J.E.L.; Araujo, F.F.; Mendes, L.W.; Van den Brink, P.J.; Araujo, A.S.F. Responses of soil microbial biomass and enzyme activity to herbicides imazethapyr and flumioxazin. Sci. Rep. 2020, 10, 7694. [Google Scholar] [CrossRef] [PubMed]
- Gousterova, A.; Nustorova, M.; Paskaleva, D.; Naydenov, M.; Neshev, G.; Vasileva-Tonkova, E. Assessment of Feather Hydrolysate from Thermophilic Actinomycetes for Soil Amendment and Biological control Application. Int. J. Environ. Res. 2011, 6, 467–474. [Google Scholar]
- Kamila, R.; Klaudia, G.; Waldemar, K.; Adam, W. Is soil management system really important? comparison of microbial community diversity and structure in soils managed under organic and conventional regimes with some view on soil properties. PLoS ONE 2021, 16, e0256969. [Google Scholar] [CrossRef]
- Lu, K.H.; Jin, Q.; Lin, Y.B.; Lu, W.W.; Li, S.S.; Zhou, C.H.; Jin, J.R.; Jiang, Q.Y.; Ling, L.C.; Xiao, M. Cell-Free Fermentation Broth of Bacillus velezensis Strain S-3-1 Improves Pak Choi Nutritional Quality and Changes the Bacterial Community Structure of the Rhizosphere Soil. Front. Microbiol. 2020, 11, 2043. [Google Scholar] [CrossRef]
- Wei, M.; Zhang, M.; Huang, G.B.; Yuan, Y.Y.; Fu, C.H.; Yu, L.J. Coculture with two Bacillus velezensis strains enhances the growth of Anoectochilus plants via promoting nutrient assimilation and regulating rhizosphere microbial community. Ind. Crops Prod. 2020, 154, 112697. [Google Scholar] [CrossRef]
- Singh, S.; Singh, U.B.; Trivdi, M.; Malviya, D.; Sahu, P.K.; Roy, M.; Sharma, P.K.; Singh, H.V.; Manna, M.C.; Saxena, A.K. Restructuring the Cellular Responses: Connecting Microbial Intervention With Ecological Fitness and Adaptiveness to the Maize (Zea mays L.) Grown in Saline-Sodic Soil. Front. Microbiol. 2021, 11, 568325. [Google Scholar] [CrossRef]

| Biocontrol Strains No. | Maximum (cm)/Minimum (cm) Radius ± SE a |
|---|---|
| 1 | 1.65 ± 0.060b |
| 2 | 1.87 ± 0.105b |
| 3 | 2.52 ± 0.134a |
| 4 | 2.26 ± 0.055a |
| 5 | 2.33 ± 0.045a |
| 6 | 1.84 ± 0.110b |
| 7 | 1.64 ± 0.075b |
| Strains | Maximum (cm)/Minimum (cm) Radius ± SE a |
|---|---|
| Fusarium solani | 1.996 ± 0.001c |
| F. equiseti | 2.321 ± 0.002a |
| F. redolens | 1.892 ± 0.001d |
| F. incarnatum | 2.256 ± 0.002b |
| F. tricinctum | 1.765 ± 0.001f |
| Chaetomium globosum | 1.820 ± 0.002e |
| F. proliferatum | 1.754 ± 0.004g |
| F. petroliphilum | 1.568 ± 0.001h |
| No. | Treatment | Application Dose | Fresh Weight (g) | Plant Height (cm) | Root Length (cm) | Disease Index (%) | Disease Reduction (%) |
|---|---|---|---|---|---|---|---|
| 1 | ii | -- | 0.09 ± 0.002b | 7.7 ± 0.69c | 5.6 ± 0.65b | 74.2 ± 0.04a | -- |
| iii | 5 mL/pot | 0.12 ± 0.01a | 12.1 ± 0.44a | 8.7 ± 0.75a | 25.6 ± 0.03b | 65.5 | |
| iv | 3 mL/pot | 0.13 ± 0.004a | 10.5 ± 1.32b | 7.9 ± 0.51a | 23.3 ± 0.10b | 68.5 | |
| v | 5 mL/pot | 0.12 ± 0.005a | 11.42 ± 0.38a | 8.5 ± 0.88a | -- | -- | |
| 2 | ii | -- | 0.09 ± 0.003b | 6.9 ± 0.19b | 5.6 ± 0.44c | 87.5 ± 0.07a | -- |
| iii | 5 mL/pot | 0.12 ± 0.003a | 11.0 ± 0.93a | 8.7 ± 0.17a | 20.6 ± 0.02b | 76.5 | |
| iv | 3 mL/pot | 0.11 ± 0.01a | 8.5 ± 0.14b | 7.0 ± 0.34b | 27.5 ± 0.01b | 68.6 | |
| v | 5 mL/pot | 0.12 ± 0.01a | 10.2 ± 0.12a | 8.2 ± 0.17a | -- | -- |
Disclaimer/Publisher’s Note: The statements, opinions and data contained in all publications are solely those of the individual author(s) and contributor(s) and not of MDPI and/or the editor(s). MDPI and/or the editor(s) disclaim responsibility for any injury to people or property resulting from any ideas, methods, instructions or products referred to in the content. |
© 2024 by the authors. Licensee MDPI, Basel, Switzerland. This article is an open access article distributed under the terms and conditions of the Creative Commons Attribution (CC BY) license (https://creativecommons.org/licenses/by/4.0/).
Share and Cite
Jiang, W.; Liu, J.; He, Y.; Payizila, A.; Li, Y. Biological Control Ability and Antifungal Activities of Bacillus velezensis Bv S3 against Fusarium oxysporum That Causes Rice Seedling Blight. Agronomy 2024, 14, 167. https://doi.org/10.3390/agronomy14010167
Jiang W, Liu J, He Y, Payizila A, Li Y. Biological Control Ability and Antifungal Activities of Bacillus velezensis Bv S3 against Fusarium oxysporum That Causes Rice Seedling Blight. Agronomy. 2024; 14(1):167. https://doi.org/10.3390/agronomy14010167
Chicago/Turabian StyleJiang, Wanyi, Jinxin Liu, Ying He, Ayihumaer Payizila, and Yonggang Li. 2024. "Biological Control Ability and Antifungal Activities of Bacillus velezensis Bv S3 against Fusarium oxysporum That Causes Rice Seedling Blight" Agronomy 14, no. 1: 167. https://doi.org/10.3390/agronomy14010167
APA StyleJiang, W., Liu, J., He, Y., Payizila, A., & Li, Y. (2024). Biological Control Ability and Antifungal Activities of Bacillus velezensis Bv S3 against Fusarium oxysporum That Causes Rice Seedling Blight. Agronomy, 14(1), 167. https://doi.org/10.3390/agronomy14010167
